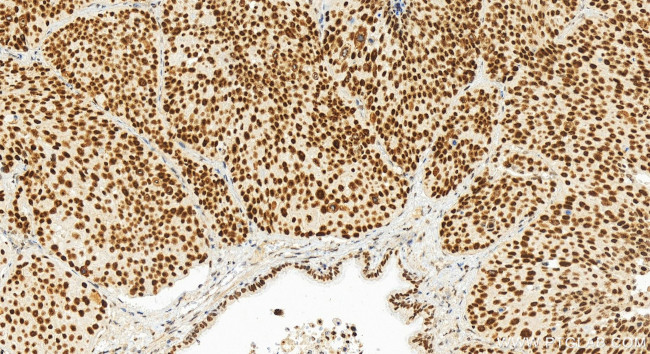
NSD3 Antibody in Immunohistochemistry (Paraffin) (IHC (P))

Search
Proteintech
NSD3 Recombinant Rabbit Monoclonal Antibody (230499C2)
{{$productOrderCtrl.translations['antibody.pdp.commerceCard.promotion.promotions']}}
{{$productOrderCtrl.translations['antibody.pdp.commerceCard.promotion.viewpromo']}}
{{$productOrderCtrl.translations['antibody.pdp.commerceCard.promotion.promocode']}}: {{promo.promoCode}} {{promo.promoTitle}} {{promo.promoDescription}}. {{$productOrderCtrl.translations['antibody.pdp.commerceCard.promotion.learnmore']}}
产品信息
83116-2-RR
种属反应
宿主/亚型
Expression System
分类
类型
克隆号
抗原
偶联物
形式
浓度
纯化类型
保存液
内含物
保存条件
运输条件
产品详细信息
Immunogen sequence: MDFSFSFMQG IMGNTIQQPP QLIDSANIRQ EDAFDNNSDI AEDGGQTPYE ATLQQGFQYP ATTEDLPPLT NGYPSSISVY ETQTKYQSYN QYPNGSANGF GAVRNFSPTD YYHSEIPNTR PHEILEKPSP PQPPPPPSVP QTVIPKKTGS PEIKLKITKT IQNGRELFES SLCGDLLNEV QASEHTKSKH ESRKEKRKKS NKHDSSRSEE RKSHKIPKLE PEEQNRPNER VDTVSEKPRE EPVLKEEAPV QPILSSVPTT EVSTGVKFQV GDLVWSKVGT YPWWPCMVSS DPQLEVHTKI
靶标信息
This gene is related to the Wolf-Hirschhorn syndrome candidate-1 gene and encodes a protein with PWWP (proline-tryptophan-tryptophan-proline) domains. The function of the protein has not been determined. Two alternatively spliced variants have been described.
仅用于科研。不用于诊断过程。未经明确授权不得转售。
篇参考文献 (0)
生物信息学
蛋白别名: DKFZp667H044; FLJ20353; Histone-lysine N-methyltransferase NSD3; MGC126766; MGC142029; nuclear receptor binding SET domain protein 3; Nuclear SET domain-containing protein 3; Protein whistle; WHSC1-like 1 isoform 9 with methyltransferase activity to lysine; WHSC1-like protein 1; Wolf-Hirschhorn syndrome candidate 1-like protein 1
基因别名: DC28; NSD3; pp14328; WHISTLE; WHSC1L1
UniProt ID: (Human) Q9BZ95
Entrez Gene ID: (Human) 54904